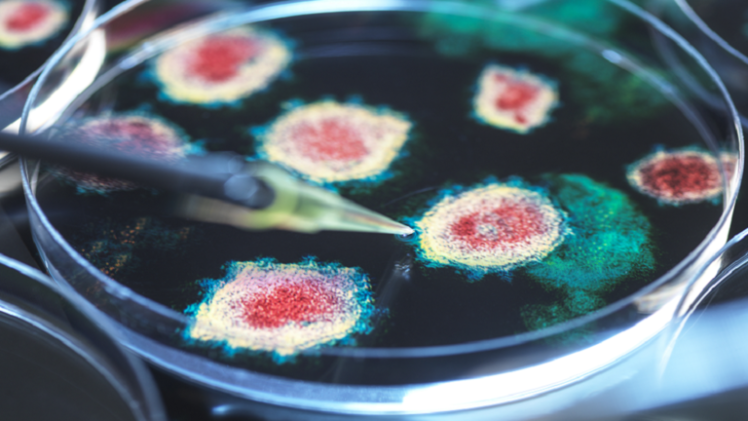

أفادت تقارير أن سلالة جديدة من فيروس كورونا يُخشى أن يكون "إيقافها أكثر صعوبة" مع زيادة مناعاتها ضد اللقاحات الحالية.
وتشكل السلالة، التي يطلق عليها FLiRT، زهاء 25% من حالات الإصابة بالمرض في الولايات المتحدة. وأفاد موقع "ديلي ستار" أن متحوّرا آخر، يُعرف باسم KP.1.1، يمثل 7.5% من الحالات الإيجابية في البلاد، مع مخاوف من انتشاره في جميع أنحاء العالم.
وقال متحدث باسم المركز الأمريكي لمكافحة الأمراض والوقاية منها: "الفيروسات تتغير باستمرار من خلال الطفرات، وفي بعض الأحيان تؤدي هذه الطفرات إلى نوع جديد من الفيروس. وتسمح بعض التغييرات والطفرات للفيروس بالانتشار بسهولة أكبر أو تجعله مقاوما للعلاجات واللقاحات. ومع انتشار الفيروس، قد يتحوّر ويصبح من الصعب إيقافه".
وزعم الدكتور إريك توبول، نائب الرئيس التنفيذي لشركة "سكريبس" للأبحاث، المطلع على السلالات الجديدة، أنها ستكون مسؤولة عن "زيادة كبيرة" في حالات المرض.
وعلى الرغم من أن فيروس كورونا دائم التطور، إلا أن الأعراض تظل كما هي إلى حد كبير.
وتشمل أعراض "كوفيد": ارتفاع درجة الحرارة أو الارتعاش والسعال الجديد والمستمر وفقدان أو تغير حاسة الشم أو التذوق وضيق التنفس، بالإضافة إلى التهاب الحلق وانسداد أو سيلان الأنف وفقدان الشهية والإسهال.